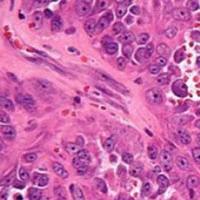
Trabectedin/Durvalumab Shows Early Activity, Demonstrates Feasibility for Soft Tissue Sarcoma
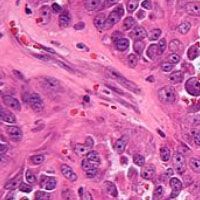

Sarcomas
Latest News
Latest Videos

CME Content
More News

In a special episode of OncLive® On Air, Shiraj Sen, MD, PhD, and Roman Groisberg, MD, highlight research evaluating combination chemotherapy regimens in the evolving sarcoma treatment paradigm.

Gary K. Schwartz, MD, highlights research that is being done with regard to genomic signatures in sarcoma, challenges faced with immunotherapy, and where the field is headed.

Despite encouraging data shown in some subtypes, there is still a lot of work that still needs to be done with determining the optimal use for immunotherapy in patients with sarcoma, a population that has historically been difficult to treat.

R. Lor Randall, MD, FACS, discusses the evolving management of desmoid fibromatosis, shares advice on the factors that go into deciding when to treat this disease, and stresses the importance of having a multidisciplinary team involved in the care of these patients.

Ripretinib demonstrated promising antitumor activity and was found to be well tolerated in patients with refractory advanced gastrointestinal stromal tumor.

Gina Z. D'Amato, MD, discusses the utility of next-generation sequencing in patients with stage I, II, or III sarcoma.

The interim futility review for the phase 2 HopES Sarcoma trial was positive and will continue to evaluate SM-88 for patients with Ewing sarcoma and other high-risk sarcomas.

John A. Abraham, MD, FACS, discusses key considerations regarding the management of tenosynovial giant cell tumor.

The FDA has granted a priority review designation to a new drug application for a unique formulation of sodium thiosulfate for the prevention of cisplatin-induced ototoxicity in patients from 1 month to less than 18 years of age with localized, nonmetastatic, solid tumors.

Jonathan C. Trent, MD, PhD, discusses the role of circulating tumor DNA in soft tissue sarcoma.

Gary K. Schwartz, MD, discusses the results from the gastrointestinal stromal tumor cohort of the phase 2 Alliance A091401 trial.

Christina L. Roland, MD, MS, FACS, discusses the safety profile of neoadjuvant checkpoint blockade in patients with undifferentiated pleomorphic sarcoma and dedifferentiated liposarcoma.

Gary K. Schwartz, MD, discusses the updated design of the phase 2 Alliance A091401 trial for metastatic sarcomas.

Gary K. Schwartz, MD, discusses future research in sarcoma.

Christina L. Roland, MD, PhD, discusses the rationale for a phase 2 study evaluating neoadjuvant checkpoint blockade study in patients with undifferentiated pleomorphic sarcoma and dedifferentiated liposarcoma.

R. Lor Randall, MD, FACS, discusses preoperative radiotherapy and how it has become a standard of care for patients with soft tissue sarcoma of the extremities; however, postoperative radiation still plays a role in the paradigm, especially when wound risks are considered to be precarious.

Christina L. Roland, MD, PhD, discusses the design of a randomized, phase 2 trial with nivolumab and ipilimumab in resectable retroperitoneal dedifferentiated liposarcoma, as well as radiation therapy in extremity/truncal undifferentiated pleomorphic sarcoma.

Gary K. Schwartz, MD, discusses the clinical findings with the combination of nivolumab and ipilimumab in patients with dedifferentiated liposarcoma and undifferentiated pleomorphic sarcoma.

The European Medicines Agency has granted access to the PRIME initiative for the Specific Peptide Enhanced Affinity Receptor T-cell therapy ADP-A2M4 for the treatment of patients with synovial sarcoma.

Alessandro Gronchi, MD, discusses the rationale for the phase 2 TRASTS study in soft tissue sarcoma.

The China National Medical Products Administration has accepted a new drug application for ripretinib as a treatment for adult patients with advanced gastrointestinal stromal tumor who have received previous treatment with 3 or more kinase inhibitors, including imatinib.

The National Comprehensive Cancer Network recently published updated Clinical Practice Guidelines in Oncology for Soft Tissue Sarcoma, listing pexidartinib as a systemic treatment for patients with tenosynovial giant cell tumor.

Gary K. Schwartz, MD, discusses results of the Alliance A091401 trial (NCT02500797) in patients with metastatic sarcoma.

R. Lor Randall, MD, FACS, discusses the need for multidisciplinary collaboration in GCTB, challenges faced in the space, and directions for future research efforts.

The European Medicines Agency’s advisory group, the Committee for Medicinal Products for Human Use, has recommended against the acceptance of the marketing authorization for pexidartinib (Turalio) for the treatment of patients with tenosynovial giant cell tumor.